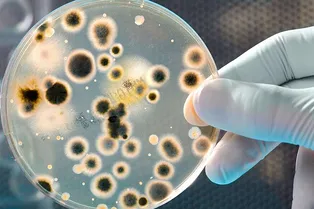

Никита Шевцев
Научный журналист, химик. Победитель VIII Всероссийского конкурса инновационной журналистики Tech in Media 2019.

Муху возрастом 47 миллионов лет обнаружили с полным брюшком

Черные дыры в центрах галактик могли возникнуть из массивных звезд в ранней Вселенной

Землеподобная экзопланета восстановила атмосферу благодаря вулканам

Из-за этой трещины от Антарктиды откололся огромный айсберг. Ученые сфотографировали ее из космоса

Студенты предложили решение проблемы квантовой теории поля

Ученые смогли восстановить нервные волокна после травмы позвоночника

В Якутске появился макет корабля «Лезвие бритвы» из «Мандалорца»

Микроскопические кротовые норы оказались возможны

Основатель Zoom передал акции стоимостью $6 миллиардов неизвестным людям

У солитонов нашли способность двигаться быстрее света

В Великобритании нашли редкий метеорит
Может ли пукание в операционной занести инфекцию в тело пациента? Врач нашел ответ на этот вопрос

У индустрии каннабиса обнаружили гигантский углеродный след

На орбите вокруг Веги нашли горячую экзопланету

Биологи нашли способ ускорить секвенирование гликозаминогликанов

На новом фотонном чипе смогли запустить несколько программ

Как безглазые черви понимают, что нужно избегать синего цвета

Искусственный интеллект составил надписи для конфет-сердечек

Физики научились передавать больше данных с помощью света
